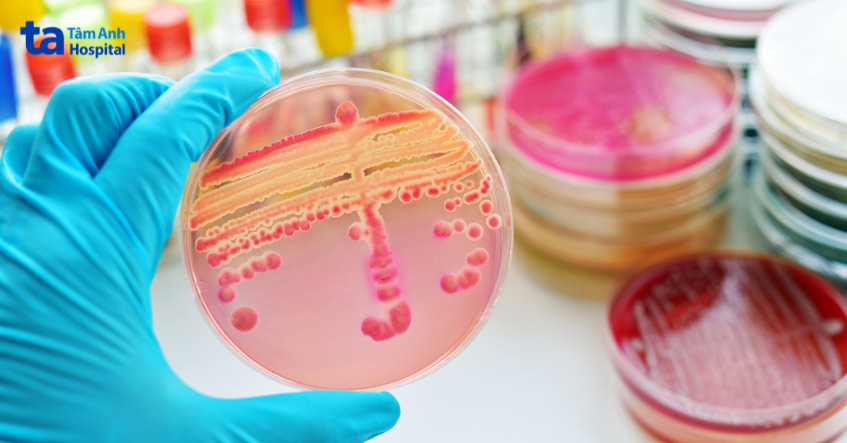
vi khuẩn neisseria gonorrhoeae gây bệnh lậu

Bệnh lậu và giang mai đều là bệnh nhiễm trùng lây qua đường tình dục (STDs). Cả 2 bệnh đều xuất hiện các triệu chứng ở vùng sinh dục khiến nhiều người lầm tưởng, không biết bệnh lậu và giang mai có giống nhau không? Phân biệt 2 bệnh này như thế nào? Trong bài viết này, BS Đoàn Ngọc Thiện, khoa Nam học, Trung tâm Tiết niệu – Thận học – Nam khoa, BVĐK Tâm Anh TP.HCM sẽ giúp bạn giải đáp thắc mắc.

Bệnh lậu và giang mai là 2 bệnh nhiễm trùng lây truyền qua đường tình dục khi quan hệ không an toàn. Nếu không được điều trị kịp thời hoặc điều trị không đáp ứng, nhiễm trùng lậu và giang mai đều dẫn đến các biến chứng nguy hiểm, không chỉ ảnh hưởng đến đời sống tình dục mà còn đe dọa đến tính mạng người bệnh.
Bệnh lậu là bệnh nhiễm trùng lây qua đường tình dục (STDs) do vi khuẩn Neisseria gonorrhoeae hoặc gonococcus có trong dịch tiết ra từ dương vật và dịch âm đạo của người bệnh. Bất cứ ai có hoạt động tình dục đều có thể mắc bệnh lậu, đặc biệt là những người thay đổi bạn tình thường xuyên hoặc không sử dụng biện pháp an toàn khi quan hệ. Người đồng tính nam, song tính có nguy cơ bị lậu cao. (1)
Vi khuẩn gây lậu đi vào cơ thể qua lối vào tử cung (cổ tử cung) và ra ngoài qua ống dẫn nước tiểu (niệu đạo), trực tràng. Con đường lây bệnh lậu chủ yếu qua:
Lậu không lây lan qua việc ôm nhau, bơi lội, ngồi toilet hoặc dùng chung bồn tắm, khăn tắm, cốc, đĩa hoặc dao kéo.
Bệnh thường được điều trị bằng tiêm kháng sinh 1 liều duy nhất. Sau điều trị, hầu hết các triệu chứng sẽ cải thiện trong vòng vài ngày. Bệnh dễ tái phát nếu người bệnh tiếp tục quan hệ tình dục không an toàn. Nhiễm lậu cầu làm tăng nguy cơ nhiễm và lây lan HIV.
Bệnh giang mai là một bệnh nhiễm trùng do vi khuẩn (xoắn khuẩn) Treponema pallidum gây ra. Bệnh bắt đầu bằng một vết loét thường không đau và thường xuất hiện ở bộ phận sinh dục, trực tràng hoặc miệng. Sau khi nhiễm trùng xảy ra, vi khuẩn giang mai có thể tồn tại trong cơ thể nhiều năm mà không gây ra triệu chứng và hoạt động trở lại ngay khi có cơ hội.
Nếu không điều trị, giang mai có thể gây tổn thương tim, não hoặc các cơ quan khác, đe dọa tính mạng. Giang mai chia thành 4 giai đoạn:
Bệnh giang mai phát triển theo từng giai đoạn. Các triệu chứng thay đổi theo từng giai đoạn. Nhưng các giai đoạn có thể chồng chéo lên nhau và các triệu chứng không phải lúc nào cũng xảy ra theo thứ tự. Một vài trường hợp có thể bị nhiễm vi khuẩn giang mai mà không nhận thấy bất kỳ triệu chứng nào trong nhiều năm. Bệnh giang mai thời kỳ I và II có thể được chữa khỏi, đôi khi chỉ bằng một mũi tiêm penicillin. (2)

Bệnh lậu và giang mai không giống nhau. Mặc dù cả 2 đều là bệnh nhiễm trùng do vi khuẩn, đều lây qua đường tình dục khi quan hệ tình dục không an toàn nhưng chúng gây ra bởi các loại vi khuẩn khác nhau và có diễn biến bệnh khác nhau.
Vi khuẩn gây lậu chủ yếu xuất hiện ở âm đạo, âm hộ, cổ tử cung (ở nữ) và đường tiết niệu (ở nam). Trong khi vi khuẩn gây giang mai gần như xuất hiện ở khắp mọi nơi trong cơ thể, nhiều nhất ở dịch tiết vết loét. (3)
Với câu hỏi “bệnh lậu và giang mai khác nhau như thế nào?” thì bệnh lậu và giang mai chủ yếu khác nhau ở: Nguyên nhân, diễn biến hay giai đoạn ủ bệnh và các triệu chứng. Cụ thể:
Bệnh lậu có nguyên nhân do vi khuẩn Neisseria gonorrhoeae hoặc gonococcus gây ra. Chúng thuộc loại vi khuẩn lưỡng bội, tồn tại thành từng cặp tế bào giống như hạt cà phê, thuộc gram âm, sinh trưởng tốt trong môi trường ấm áp, ẩm ướt.
Bệnh giang mai là do một loại vi khuẩn có tên Treponema pallidum gây ra, nó thường được gọi là xoắn khuẩn vì có dạng xoắn ốc như lò xo. Vi khuẩn gây giang mai cũng thuộc loại gram âm, nhưng rất mỏng và khó nhuộm bằng các phương pháp xét nghiệm nhuộm gram hơn so với vi khuẩn lậu.
Thời kỳ ủ bệnh của lậu thường ngắn, từ 1 – 14 ngày. Hầu hết các trường hợp mắc bệnh lậu đều xuất hiện các triệu chứng đầu tiên trong vòng 2 – 5 ngày, kể từ khi phơi nhiễm.
Trong khi đó, giang mai có thời gian ủ bệnh kéo dài từ 10 – 90 ngày, lâu hơn so với bệnh lậu. Hầu hết các trường hợp nhiễm xoắn khuẩn Treponema pallidum thường xuất hiện triệu chứng đầu tiên sau khoảng 21 ngày nhiễm bệnh.
Triệu chứng điển hình của bệnh lậu bao gồm:
Các triệu chứng điển hình của giang mai bao gồm:
> Xem thêm chi tiết 5 giai đoạn phát triển bệnh giang mai có thể bạn bạn quan tâm!!
Nên quan hệ tình dục an toàn để phòng tránh lậu, giang mai. Bệnh lậu và giang mai chủ yếu lây qua đường tình dục, khi quan hệ không an toàn. Cho nên cách tốt nhất để tránh lậu và giang mai chính là thực hiện các biện pháp an toàn khi quan hệ, sống chung thủy 1 vợ 1 chồng.
Không có cách nào có thể phòng tránh tuyệt đối lậu và giang mai khi vẫn duy trì các hoạt động trong đời sống tình dục. Tuy nhiên, thực hiện các biện pháp an toàn khi quan hệ tình dục có thể làm giảm đáng kể nguy cơ nhiễm trùng lậu và giang mai.

Nhằm tìm ra xoắn khuẩn gây bệnh trong mẫu thử là máu, dịch tiết, huyết tương của người bệnh, chẩn đoán nhanh và chính xác tình trạng bệnh. Xét nghiệm trực tiếp bao gồm:
Đối với bệnh lậu, NAAT thường có thể phát hiện nhiễm trùng trong vòng vài ngày đến 1 tuần. Nhưng ở bệnh giang mai, có thể mất vài tuần đến vài tháng trước khi xét nghiệm cho kết quả dương tính. Cả bệnh lậu và giang mai đều có thể điều trị được bằng kháng sinh. Chẩn đoán và điều trị sớm là cần thiết để ngăn ngừa biến chứng.
Cả bệnh lậu và giang mai đều có thể điều trị được bằng kháng sinh. Đối với bệnh lậu, Trung tâm Kiểm soát và Phòng ngừa Dịch bệnh (CDC) khuyến cáo điều trị lậu bằng 1 liều tiêm ceftriaxone. Trong một số trường hợp, 1 liều doxycycline uống cũng có thể được kê đơn để giải quyết khả năng đồng nhiễm chlamydia.
Việc điều trị bệnh giang mai tùy thuộc vào giai đoạn nhiễm trùng. Bệnh giang mai thời kỳ I, II hoặc tiềm ẩn sớm có thể được điều trị bằng 1 mũi tiêm bắp benzathine penicillin G. Bệnh giang mai tiềm ẩn muộn hoặc thời kỳ III cần dùng nhiều liều benzathine penicillin G trong vài tuần để loại bỏ nhiễm trùng.
Tuy nhiên, theo thời gian, vi khuẩn gây bệnh lậu, giang mai đã phát triển khả năng kháng lại nhiều loại kháng sinh điều trị. Cho nên, mỗi người bệnh cần được chẩn đoán tình trạng nhiễm trùng hiện tại, tuân thủ những chỉ định về điều trị của bác sĩ. Đảm bảo hiệu quả loại bỏ vi khuẩn gây bệnh và ngăn ngừa sự phát triển của tình trạng kháng thuốc. Bạn tình cần được xét nghiệm, điều trị để ngăn ngừa tái nhiễm và lây lan bệnh.
Bệnh lậu và giang mai là 2 bệnh hoàn toàn khác nhau, do 2 loại nhiễm trùng khác nhau gây ra và lây truyền chủ yếu qua đường tình dục. Vì không phải 2 bệnh này lúc nào cũng xuất hiện triệu chứng, nên xét nghiệm là cách duy nhất để biết chắc chắn 1 người có bị nhiễm lậu hoặc giang mai hay không. Phát hiện và điều trị kịp thời lậu, giang mai và các nhiễm trùng lây truyền qua đường tình dục khác là cách tốt nhất để có đời sống tình dục viên mãn và bảo vệ sức khỏe bản thân.
Khoa Nam học, Trung tâm Tiết niệu – Thận học – Nam khoa, BVĐK Tâm Anh là địa chỉ được nhiều người bệnh tin tưởng, lựa chọn để chẩn đoán, xét nghiệm sàng lọc các nhiễm trùng và các bệnh lây qua đường tình dục, trong đó có lậu và giang mai.
HỆ THỐNG BỆNH VIỆN ĐA KHOA TÂM ANH
Hy vọng với những thông tin mà bài viết vừa chia sẻ đã mang đến nhiều thông tin hữu ích, giúp bạn hiểu được bệnh lậu và giang mai có giống nhau không? Cách phân biệt 2 loại nhiễm trùng này. Lậu, giang mai và các nhiễm trùng lây qua đường tình dục khác cần được phát hiện sớm và điều trị kịp thời, bảo vệ sức khỏe toàn diện và nâng cao chất lượng cuộc sống.